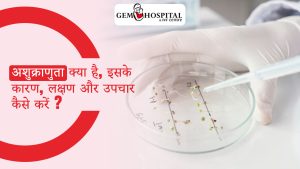
अशुक्राणुता क्या है, इसके कारण, लक्षण और उपचार कैसे करें ?

Punjab’s
Most Trusted IVF Specialist
40 Feet Road, Namdev Marg,
Bathinda, Punjab 151001

In Vitro Fertilization (IVF)

Egg Donation & Fertility Support

Cryopreservation of Sperm

WHO ARE WE
Why GEM IVF Is One of India’s Best IVF Centers
12,000+
Happy Couples Treated
20+ Years
Experienced Fertility Experts
88%+
IVF Success Rate
24×7
Support & Care
OUR SERVICES
IUI
IUI is a fertility treatment where sperm is placed directly into the uterus around the time of ovulation, increasing the chances of conception. This procedure is ideal for couples facing mild infertility issues.
ICSI
ICSI is an advanced IVF technique where a single sperm is injected directly into the egg, overcoming male infertility factors. It offers a high success rate, particularly for male factor infertility.
Laparoscopy
Laparoscopy is a minimally invasive surgery used to diagnose and treat various gynecological conditions like endometriosis and blocked fallopian tubes, improving fertility outcomes.
Embryo Donation
Embryo donation is a fertility treatment option for couples who are unable to produce viable eggs or sperm. Donated embryos are implanted into the recipient’s uterus to achieve pregnancy.
Blastocyst Culture
Blastocyst culture involves growing embryos to the blastocyst stage before implantation. This helps in selecting the most viable embryos, increasing the chances of successful pregnancy.
Hysteroscopy
Hysteroscopy is a minimally invasive procedure used to examine and treat issues inside the uterus, such as fibroids, polyps, or adhesions, improving fertility outcomes.
PCOS
PCOS is a common cause of infertility. We offer tailored treatments to regulate hormonal imbalances and restore ovulation, helping women with PCOS achieve successful pregnancies.
Azoospermia
Azoospermia is the absence of sperm in semen. At Gem Hospital, we offer advanced treatments like PESA and TESA to retrieve sperm directly from the testes, making it possible to use sperm for ICSI or IVF.
PESA
PESA is a procedure where sperm is directly aspirated from the epididymis using a needle. This is an effective option for men with azoospermia who cannot produce sperm in their semen.
TESA
TESA is a procedure where sperm is retrieved directly from the testes for use in IVF or ICSI, offering hope to men with severe sperm production issues.
Egg Donation
Egg donation is a fertility option where a donor’s eggs are used in IVF. This is an ideal solution for women with diminished ovarian reserve or genetic conditions that affect egg quality.
Family planning
Bank as well know is a place to store or reserve something valuable which can be advantageous for future use. Semen Banking or Semen Freezing and also called Semen Cryopreservation is a method of storing semen for future use.
SUCCESS STORIES FROM HAPPY PATIENTS




Understanding Treatments with Dr. Neera Gupta
OUR TREATMENTS
IVF (In vitro fertilization)
IVF is a revolutionary treatment for infertility, where an egg is fertilized outside the body and then implanted into the uterus. It’s an ideal option for women with blocked fallopian tubes, severe male infertility, or other reproductive challenges.
IUI is a simple and effective fertility treatment where sperm is directly placed into the uterus to improve the chances of conception, particularly for women with ovulation disorders or male factor infertility.
ICSI is a technique used during IVF to inject a single sperm directly into an egg. This method is often used when there are male infertility issues, offering a higher success rate for fertilization.
Egg donation is a fertility treatment for women who cannot use their own eggs due to age, genetics, or other health issues. Donated eggs are fertilized and implanted to achieve pregnancy.
Blastocyst culture allows embryos to develop for longer before implantation, increasing the chances of selecting the most viable embryos, improving IVF success rates.
Semen banking is an option for men who wish to preserve their sperm for future use, especially in cases of medical treatments like chemotherapy or for those who face fertility issues.
Laparoscopy is a minimally invasive surgical technique used to treat a variety of reproductive health conditions. It helps in diagnosing and treating issues like blocked fallopian tubes or endometriosis, improving fertility outcomes.
Embryo donation is an effective solution for couples who are unable to produce viable eggs or sperm. The donated embryos are implanted into the recipient’s uterus, offering the possibility of parenthood.
Hysteroscopy is a procedure that involves examining the uterus with a small camera to diagnose and treat uterine conditions such as fibroids, polyps, or scarring, which may affect fertility.
Why Choose Gem Hospital and IVF Centre
Advanced IVF Technology
We use the latest IVF technology and techniques to provide the best chance of success. Our state-of-the-art laboratory and equipment ensure precise and effective treatments.
Specialist Doctors To Serve You
Our team of experienced and compassionate doctors, led by Dr. Neera Gupta, are experts in fertility treatments and are committed to helping you achieve your dream of parenthood.
24/7 Emergency Help
We offer round-the-clock emergency diagnostic services to support you in urgent situations, ensuring you receive timely and reliable care when needed most.
ISO 9001:2015 Certification
Gem Hospital & IVF Centre is ISO certified, demonstrating our commitment to maintaining the highest standards of quality care and patient safety.

IVF Frequently Asked Questions
What is IVF, and how does it work?
IVF involves fertilizing an egg with sperm outside the body and implanting the embryo into the uterus. It is used for various infertility issues like blocked fallopian tubes or male infertility.
How long does IVF treatment take?
IVF typically takes about 4-6 weeks, including ovarian stimulation, egg retrieval, fertilization, embryo transfer, and the pregnancy test.
What is IUI and when is it recommended?
IUI is a fertility treatment where sperm is placed directly into the uterus. It is recommended for couples with unexplained infertility or mild male infertility.
Is IVF painful?
IVF involves some discomfort, especially during egg retrieval, but it is generally well-tolerated. Anesthesia is provided for comfort during procedures.
What are the success rates of IVF?
Success rates vary based on age, infertility causes, and other factors, but the overall IVF success rate is around 40-50% per cycle for women under 35.
What is ICSI, and why is it used?
ICSI is a technique where a single sperm is injected directly into an egg. It is used when there are severe male infertility issues or previous fertilization failures with traditional IVF.
Can I get pregnant using donated eggs?
Yes, egg donation is an effective option for women who are unable to use their eggs. The donated eggs are fertilized and implanted into the uterus.
What is laparoscopy, and how does it help with fertility?
Laparoscopy is a minimally invasive surgery used to treat conditions like endometriosis and blocked fallopian tubes, which can affect fertility.
How do I know if IVF is right for me?
Your fertility specialist will evaluate your medical history, conduct tests, and recommend the best treatment option based on your condition.
Is there any risk associated with IVF treatment?
Like any medical procedure, IVF carries some risks, such as ovarian hyperstimulation syndrome (OHSS), multiple pregnancies, and complications from egg retrieval. Your doctor will discuss these with you beforehand.
Looking for IVF Specialist?
Talk to Our IVF Doctors
RECENT BLOG

PCOD/PCOS: लक्षण, उपचार और जीवनशैली प्रबंधन की सम्पूर्ण गाइड

संतान सुख की ओर एक कदम: IVF प्रक्रिया की पूरी जानकारी